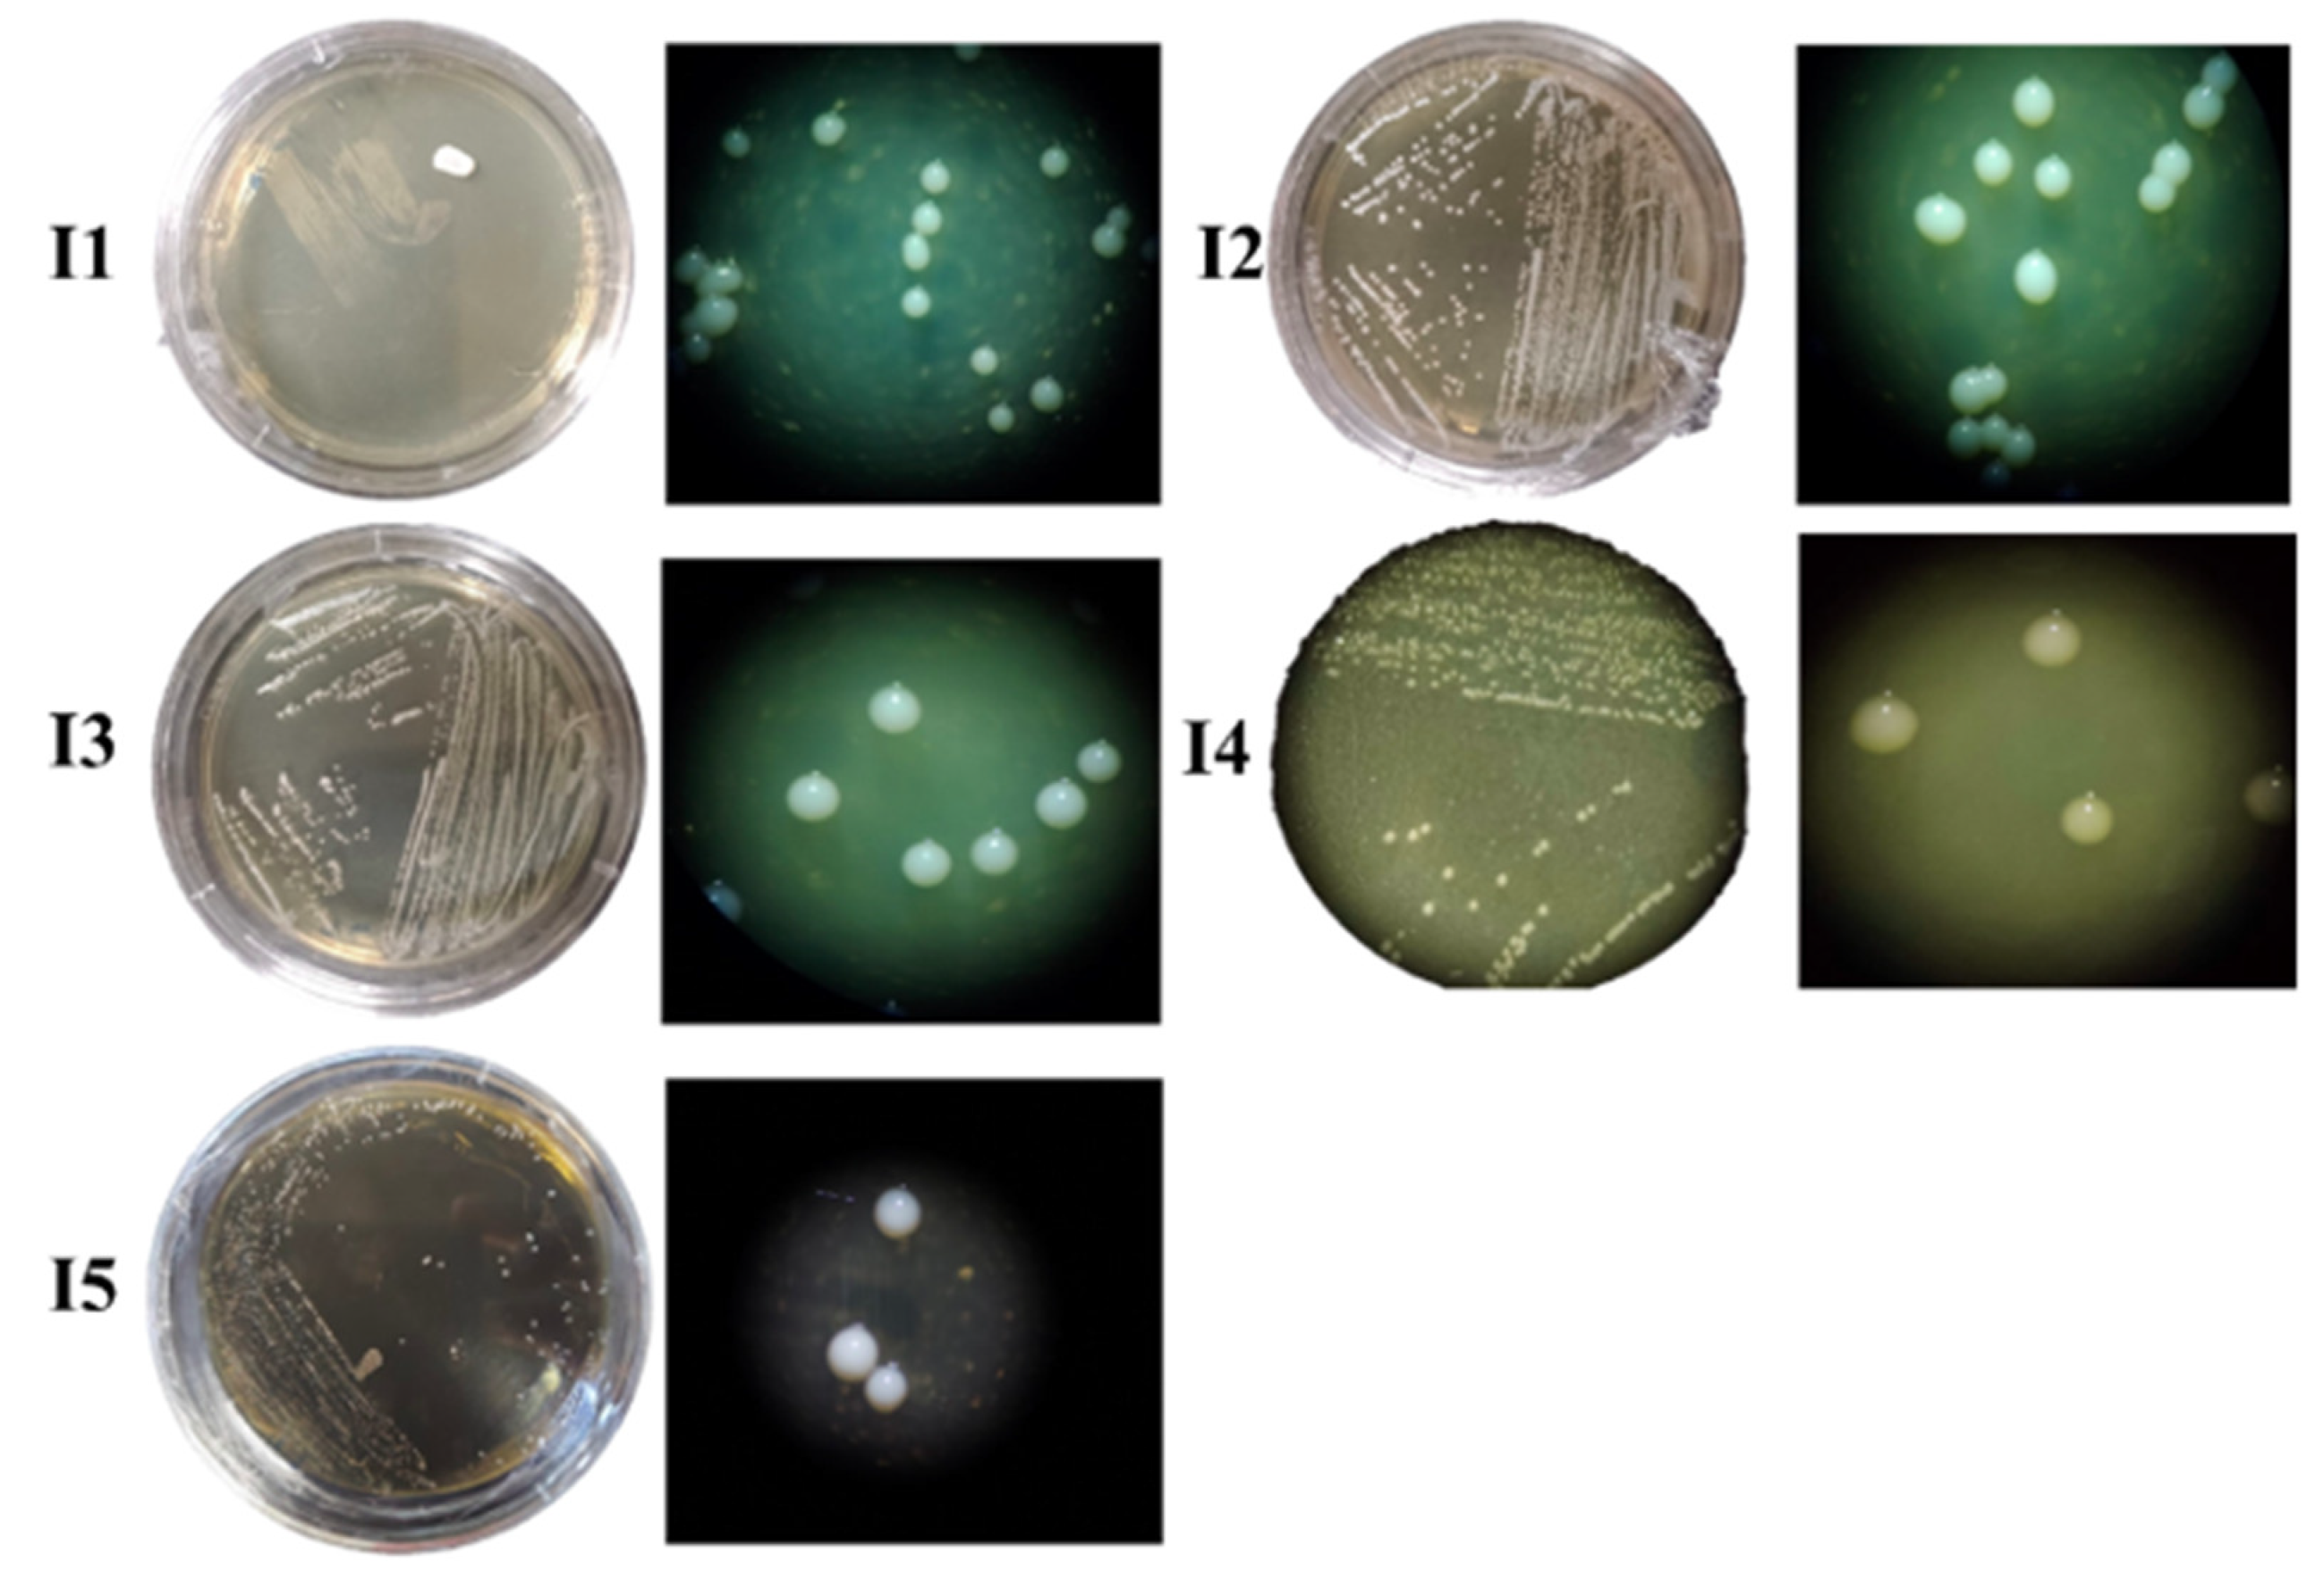
Microorganisms 12 02236 g003

Study of Bacillus cereus as an Effective Multi-Type A Trichothecene Inactivator
Abstract
1. Introduction
2. Materials and Methods
2.1. Mycotoxin Production, Isolation, and Quantification
2.2. Bacterial Consortium
2.2.1. Broiler Proventriculus Facultative Anaerobe Bacteria
2.2.2. Enrichment of the Bacterial Consortium and Removal of Mycotoxins
2.3. Bacterial Isolates
2.3.1. Purification of Bacterial Isolates
2.3.2. Morphological Structure of Bacterial Isolates
2.3.3. Effect of the Bacterial Isolates on Mycotoxin Removal
2.3.4. Molecular Characterization of Isolates
2.4. Single Bacteria Characterization
2.4.1. Biochemical Tests
2.4.2. Biosorption Assay
2.5. Statistical Analysis
3. Results
3.1. Mycotoxin Production, Isolation, and Quantification
3.2. Bacterial Consortium
3.2.1. Effect of Facultative Anaerobe Bacteria Consortium on T-2 Mycotoxin Removal
3.2.2. Effect of Facultative Anaerobe Bacteria Consortium on HT-2 Mycotoxin Removal
3.2.3. Effect of Facultative Anaerobe Bacteria Consortium on NEO Mycotoxin Removal
3.3. Bacterial Isolates
3.3.1. Morphological Structure of Bacterial Isolates
3.3.2. Molecular Characterization of Isolates
3.3.3. Effect of Bacterial Isolates on Mycotoxin Concentration
- T-2. While I3, I4, and I5 reduced T-2 toxin concentration (26.52%, 18.70%, and 28.35%; Figure 7) when compared to C; I1 and I2 incremented the T-2 toxin concentration compared to C.
- HT-2. I1, I3, I4, and I5 reduced the HT-2 toxin concentration (28.27%, 1.99%, 1.38%, and 32.84%) when compared to C. I2 slightly incremented the HT-2 toxin compared to C (Figure 7).
- NEO. I5 was the only strain that reduced the NEO concentration by 27.14% compared to C. In contrast, the rest of the isolates increased the NEO concentration when compared to C (Figure 7).
3.4. Single Bacteria
3.4.1. Biochemical Tests
3.4.2. Biosorption Assay
4. Discussion
5. Conclusions
Author Contributions
Funding
Data Availability Statement
Acknowledgments
Conflicts of Interest
References
- Nawaf, A. Mycotoxin source and its exposure causing mycotoxicoses. Bioinformation 2023, 19, 348–357. [Google Scholar] [PubMed]
- Bryden, W.L. Mycotoxins in the food chain: Human health implications. Asia Pac. J. Clin. Nutr. 2007, 16, 95–101. [Google Scholar] [PubMed]
- Awuchi, C.G.; Ondari, E.N.; Ogbonna, C.U.; Upadhyay, A.K.; Baran, K.; Okpala, C.O.R.; Korzeniowska, M.; Guiné, R.P.F. Mycotoxins affecting animals, foods, humans, and plants: Types, occurrence, toxicities, action mechanisms, prevention, and detoxification strategies—A Revisit. Foods 2021, 10, 1279. [Google Scholar] [CrossRef] [PubMed]
- Stein, R.A.; Bulcoaca, A.E. Mycotoxins. In Foodborne Diseases, 3rd ed.; Chapter 21; Academic Press: Cambridge, MA, USA, 2017; pp. 407–446. [Google Scholar]
- Murphy, P.A.; Hendrich, S.; Landgren, C.; Bryant, C.M. Food Mycotoxins: An update. J. Food Sci. 2006, 71, R51–R65. [Google Scholar] [CrossRef]
- Paterson, R.R.M.; Lima, N. Toxicology of mycotoxins. Galanin 2010, 100, 31–63. [Google Scholar]
- Mahato, D.K.; Pandhi, S.; Kamle, M.; Gupta, A.; Sharma, B.; Panda, B.K.; Srivastava, S.; Kumar, M.; Selvakumar, R.; Pandey, A.K.; et al. Trichothecenes in food and feed: Occurrence, impact on human health and their detection and management strategies. Toxicon 2022, 208, 62–77. [Google Scholar] [CrossRef]
- Mostrom, M.S.; Raisbeck, M.F. Trichothecenes. In Veterinary Toxicology; Gupta, R., Ed.; Elsevier Inc.: New York, NY, USA, 2007; pp. 951–976. [Google Scholar]
- McCormick, S.P.; Stanley, A.M.; Stover, N.A.; Alexander, N.J. Trichothecenes: From simple to complex mycotoxins. Toxins 2011, 3, 802–814. [Google Scholar] [CrossRef]
- Macri, A.M.; Nagy, A.L.; Daina, S.; Toma, D.; Pop, I.D.; Nadăș, G.C.; Cătoi, A.F. Occurrence of types A and B trichothecenes in cereal products sold in romanian markets. Toxins 2023, 15, 466. [Google Scholar] [CrossRef]
- Zhang, J.; Zhang, H.; Liu, S.; Wu, W.; Zhang, H. Comparison of anorectic potencies of type A trichothecenes T-2 toxin, HT-2 toxin, diacetoxyscirpenol, and neosolaniol. Toxins 2018, 10, 179. [Google Scholar] [CrossRef]
- Polak-Śliwińska, M.; Paszczyk, B. Trichothecenes in food and feed, relevance to human and animal health and methods of detection: A systematic review. Molecules 2021, 26, 454. [Google Scholar] [CrossRef]
- Karlovsky, P.; Suman, M.; Berthiller, F.; De Meester, J.; Eisenbrand, G.; Perrin, I.; Oswald, I.P.; Speijers, G.; Chiodini, A.; Recker, T.; et al. Impact of food processing and detoxification treatments on mycotoxin contamination. Mycotoxin Res. 2016, 32, 179–205. [Google Scholar] [CrossRef] [PubMed]
- Chen, P.; Xiang, B.; Shi, H.; Yu, P.; Song, Y.; Li, S. Recent advances on type A trichothecenes in food and feed: Analysis, prevalence, toxicity, and decontamination techniques. Food Control 2020, 118, 107371. [Google Scholar] [CrossRef]
- Orozco-Cortés, P.C.; Flores-Ortíz, C.M.; Hernández-Portilla, L.B.; Vázquez, M.J.; Rodríguez-Peña, O.N. Molecular docking and in vitro studies of ochratoxin A (OTA) biodetoxification testing three endopeptidases. Molecules 2023, 28, 2019. [Google Scholar] [CrossRef]
- Zhu, Y.; Hassan, Y.I.; Lepp, D.; Shao, S.; Zhou, T. Strategies and methodologies for developing microbial detoxification systems to mitigate mycotoxins. Toxins 2017, 9, 130. [Google Scholar] [CrossRef]
- Vila-Donat, P.; Marín, S.; Sanchis, V.; Ramos, A.J. A review of the mycotoxin adsorbing agents, with an emphasis on their multi-binding capacity, for animal feed decontamination. Food Chem. Toxicol. 2018, 114, 246–259. [Google Scholar] [CrossRef]
- Taheur, F.B.; Kouidhi, B.; Quarashi, Y.M.A.; Salah-Abbès, J.B.; Chaieb, K. Review: Biotechnology of mycotoxins detoxification using microorganisms and enzymes. Toxicon 2019, 160, 12–22. [Google Scholar] [CrossRef]
- Xu, J.; Zhao, Z.; Guo, W.; Ling, A.; Wang, J.; Wang, X.; Yang, J. Potential role of individual and combined effects of T-2 toxin, HT-2 toxin and neosolaniol on the apoptosis of porcine leydig cells. Toxins 2022, 14, 145. [Google Scholar] [CrossRef]
- Ndiaye, S.; Zhang, M.; Fall, M.; Ayessou, N.M.; Zhang, Q.; Li, P. Current review of mycotoxin biodegradation and bioadsorption: Microorganisms, mechanisms, and main important applications. Toxins 2022, 14, 729. [Google Scholar] [CrossRef]
- Young, J.C.; Zhou, T.; Yu, H.; Zhu, H.; Gong, J. Degradation of trichothecene mycotoxins by chicken intestinal microbes. Food Chem. Toxicol. 2007, 45, 136–143. [Google Scholar] [CrossRef]
- Cserháti, M.; Kriszt, B.; Krifaton, C.; Szoboszlay, S.; Háhn, J.; Tóth, S.; Nagy, I.; Kukolya, J. Mycotoxin-degradation profile of Rhodococcus strains. Int. J. Food Microbiol. 2013, 166, 176–185. [Google Scholar] [CrossRef]
- Wang, Y.; Zhao, C.; Zhang, D.; Zhao, M.; Zheng, D.; Peng, M.; Cheng, W.; Guo, P.; Cui, Z. Simultaneous degradation of aflatoxin B1 and zearalenone by a microbial consortium. Toxicon 2018, 146, 69–76. [Google Scholar] [CrossRef] [PubMed]
- Wang, X.; Qin, X.; Hao, Z.; Luo, H.; Yao, B.; Su, X. Degradation of four major mycotoxins by eight manganese peroxidases in presence of a dicarboxylic acid. Toxins 2019, 11, 566. [Google Scholar] [CrossRef] [PubMed]
- Topcu, A.; Bulat, T.; Wishah, R.; BoyacI, I.H. Detoxification of aflatoxin B1 and patulin by Enterococcus faecium strains. Int. J. Food Microbiol. 2010, 139, 202–205. [Google Scholar] [CrossRef]
- He, W.J.; Yuan, Q.S.; Zhang, Y.B.; Guo, M.W.; Gong, A.D.; Zhang, J.B.; Wu, A.B.; Huang, T.; Qu, B.; Li, H.P.; et al. Aerobic de-epoxydation of trichothecene mycotoxins by a soil bacterial consortium isolated ising in situ soil enrichment. Toxins 2016, 8, 277. [Google Scholar] [CrossRef]
- Juodeikiene, G.; Bartkiene, E.; Cernauskas, D.; Cizeikiene, D.; Zadeike, D.; Lele, V.; Bartkevics, V. Antifungal activity of lactic acid bacteria and their application for Fusarium mycotoxin reduction in malting wheat grains. LWT 2018, 89, 307–314. [Google Scholar] [CrossRef]
- Wang, Y.; Wang, G.; Dai, Y.; Wang, Y.; Lee, Y.-W.; Shi, J.; Xu, J. Biodegradation of deoxynivalenol by a novel microbial consortium. Front. Microbiol. 2020, 10, 2964. [Google Scholar] [CrossRef]
- Hathout, A.S.; Aly, S.E. Biological detoxification of mycotoxins: A review. Ann. Microbiol. 2014, 64, 905–919. [Google Scholar] [CrossRef]
- Qiu, Y.; Yan, J.; Yue, A.; Lu, Z.; Tan, J.; Guo, H.; Ding, Y.; Lyu, F.; Fu, Y. A comprehensive review of biodetoxification of trichothecenes: Mechanisms, limitations and novel strategies. Food Res. Int. 2024, 184, 114275. [Google Scholar] [CrossRef]
- Novak, B.; Lopes, H.A.; Ghanbari, M.; Mayumi, M.V.; Bracarense, A.P.F.R.L.; Neves, M.; Emsenhuber, C.; Wein, S.; Oswald, I.P.; Pinton, P.; et al. Effects of Fusarium metabolites beauvericin and enniatins alone or in mixture with deoxynivalenol on weaning piglets. Food Chem. Toxicol. 2021, 158, 112719. [Google Scholar]
- Gao, X.; Mu, P.; Wen, J.; Sun, Y.; Chen, Q.; Deng, Y. Detoxification of trichothecene mycotoxins by a novel bacterium, Eggerthella sp. DII-9. Food Chem. Toxicol. 2018, 112, 310–319. [Google Scholar] [CrossRef]
- Böhm, J.; Grajewski, J.; Asperger, H.; Cecon, B.; Rabus, B.; Razzazi, E. Study on biodegradation of some A- and B-trichothecenes and ochratoxin A by use of probiotic microorganisms. Mycotoxin Res. 2000, 16 (Suppl. S1), 70–74. [Google Scholar] [CrossRef] [PubMed]
- Summerell, B.A.; Salleh, B.; Leslie, J.F. A utilitarian approach to Fusarium identification. Plant Dis. 2003, 2, 117–128. [Google Scholar] [CrossRef] [PubMed]
- Landa, M.P. Análisis de Toxina T2 en Cereales Mediante Inserción Directa en Espectrometría de Masas. Bachelor’s Thesis, Facultad de Química, UNAM, Mexico City, Mexico, 2003; 58p. [Google Scholar]
- García-García, F.A.; Cristiani-Urbina, E.; Morales-Barrera, L.; Rodríguez-Peña, O.N.; Hernández-Portilla, L.B.; Flores-Ortíz, C.M. Spectroscopic and microestructural evidence for T-2 toxin adsorption mechanism by natural bentonite modified with organic cations. Toxins 2023, 15, 470. [Google Scholar] [CrossRef]
- PROY-NOM-194-SSA1-2000; Especificaciones Sanitarias en los Establecimientos Dedicados al Faenado de Animales Para Abasto, Corte, Deshuese, Envasado, Almaceny Expendio. Especificaciones Sanitarias de Productos. Secretaria de Salud: Ciudad de México, México, 2000.
- NOM-110-SSA1-1994; Bienes y Servicios. Preparación y Dilución de Muestras de Alimentos para su Análisis Microbiológico. Secretaría de Salud: Ciudad de México, México, 1994.
- Paray, A.A.; Singh, M.; Mir, M.A.; Kaur, A. Gram Staining: A Brief Review. Int. J. Res. Rev. 2023, 10, 336–341. [Google Scholar] [CrossRef]
- Ho, K.C.; Hwa, S.H.; Seoul, J.K.; Gyeong, Y.K.; Jeong, Y.; Min, H.P.; Soo, N.P. Inhibition of Nitric Oxide Production, Oxidative Stress Prevention, and Probiotic Activity of Lactic Acid Bacteria isolated from the Human Vagina and Fermented Food. Microorganisms 2019, 7, 109. [Google Scholar] [CrossRef]
- Holben, W.E.; Feris, K.P.; Kettunen, A.; Apajalahti, J. GC fractionation enhances microbial community diversity assessment and detection of minority populations of bacteria by denaturing gradient gel electrophoresis. Appl. Environ. Microbiol. 2004, 68, 5918–5924. [Google Scholar]
- Salas, J. Flavonoides de Prosopis Laevigata (Mezquite) Inductores de Genes nod de Rizobios. Master’s Thesis, Facultad de Estudios Superiores Iztacala, UNAM, Mexico City, Mexico, 2013; 80p. [Google Scholar]
- Zhou, H.; Gong, J.; Brisbin, J.T.; Yu, H.; Sanse, B.; Sabour, P.; Sharif, S. Appropriate chicken sample size for identifying the composition of broiler intestinal microbiota affected by dietary antibiotics, using the polymerase chain reaction-denaturing gradient gel electrophoresis technique. Poult. Sci. 2007, 86, 2541–2549. [Google Scholar] [CrossRef]
- Hall, B.G. Building phylogenetic trees from molecular data with MEGA. Mol. Biol. Evol. 2013, 30, 1229–1235. [Google Scholar] [CrossRef]
- Tsega, K.T.; Maina, K.J.; Tesema, N.B. Characterization of potential probiotics Lactobacillus species isolated from the gastrointestinal tract of Rhode Island Red (RIR) chicken in Ethiopia. Heliyon 2023, 9, e17453. [Google Scholar] [CrossRef]
- Bergey, H.; .John, G. Bergey’s Manual of Determinative Bacteriology, 9th ed.; Williams and Wilkins: Baltimore, MD, USA, 1994; 787p. [Google Scholar]
- Barrow, G.I.; Feltham, R.K.A. Cowan and Steel’s Manual for the Identification of Medical Bacteria, 3rd ed.; Cambridge University Press: Cambridge, UK, 2003. [Google Scholar]
- Zar, J.H. Biostatistical Analysis; Prentice-Hall, Inc.: Upper Saddle River, NJ, USA, 1996. [Google Scholar]
- Meneely, J.; Greer, B.; Kolawole, O.; Elliott, C. T-2 and HT-2 toxins: Toxicity, occurrence and analysis: A Review. Toxins 2023, 15, 481. [Google Scholar] [CrossRef]
- Ling, A.; Sun, L.; Guo, W.; Sun, S.; Yang, J.; Zhao, Z. Individual and combined cytotoxic effects of T-2 toxin and its four metabolites on porcine Leydig cells. Food Chem. Toxicol. 2020, 139, 111277. [Google Scholar] [CrossRef] [PubMed]
- Xu, H.; Wang, L.; Sun, J.; Wang, L.; Guo, H.; Ye, Y.; Sun, X. Microbial detoxification of mycotoxins in food and feed. Crit. Rev. Food Sci. Nutr. 2022, 62, 4951–4969. [Google Scholar] [CrossRef] [PubMed]
- Torp, M.; Langseth, W. Production of T-2 toxin by a Fusarium resembling Fusarium poae. Mycopathologia 1999, 147, 89–96. [Google Scholar] [CrossRef]
- Li, Y.; Wang, Z.; Beier, R.C.; Shen, J.; De Smet, D.; De Saeger, S.; Zhang, S. T-2 toxin, a trichothecene mycotoxin: Review of toxicity, metabolism, and analytical methods. J. Agric. Food Chem. 2011, 59, 3441–3453. [Google Scholar] [CrossRef]
- Nathanail, A.V.; Varga, E.; Reiterer, J.M.; Bueschl, C.; Michlmayr, H.; Malachova, A.; Fruhmann, P.; Jestoi, M.; Peltonen, K.; Adam, G.; et al. Metabolism of the Fusarium mycotoxins T-2 toxin and HT-2 toxin in wheat. J. Agric. Food Chem. 2015, 63, 7862–7872. [Google Scholar] [CrossRef]
- Yagen, B.; Bialer, M. Metabolism and pharmacokinetics of T-2 toxin and related trichothecenes. Drug Metab. Rev. 1993, 25, 281–323. [Google Scholar] [CrossRef]
- Nesic, K.; Ivanovic, S.; Nesic, V. Fusarial toxins: Secondary metabolites of Fusarium fungi. Rev. Environ. Contam. 2013, 228, 101–120. [Google Scholar]
- Kokkonen, M.; Jestoi, M.; Laitila, A. Mycotoxin production of Fusarium langsethiae and Fusarium sporotrichioides on cereal-based substrates. Mycotoxin Res. 2011, 28, 25–35. [Google Scholar] [CrossRef]
- Desjardins, A.E. Fusarium Mycotoxins: Chemistry, Genetics and Biology; The American Phytopathological Society: St Paul, MN, USA, 2006; p. 260. [Google Scholar]
- Yu, H.; Zhou, T.; Gong, J.; Young, C.; Su, X.; Li, X.-Z.; Zhu, H.; Tsao, R.; Yang, R. Isolation of deoxynivalenol-transforming bacteria from the chicken intestines using the approach of PCR-DGGE guided microbial selection. BMC Microbiol. 2010, 10, 182. [Google Scholar] [CrossRef]
- Nahle, S.; ElKhoury, A.; Savvaidis, I.; Chokr, A.; Louka, N.; Atoui, A. Detoxification approaches of mycotoxins by microorganisms, biofilms and enzymes. Food Contam. 2022, 9, 3. [Google Scholar] [CrossRef]
- Jia, S.; Ren, C.; Yang, P.; Qi, D. Effects of intestinal microorganisms on metabolism and toxicity mitigation of zearalenone in broilers. Animals 2022, 12, 1962. [Google Scholar] [CrossRef] [PubMed]
- Efremenko, E.; Senko, O.; Maslova, O.; Lyagin, I.; Aslanli, A.; Stepanov, N. Destruction of mycotoxins in poultry waste under anaerobic conditions within methanogenesis catalyzed by artificial microbial consortia. Toxins 2023, 15, 205. [Google Scholar] [CrossRef] [PubMed]
- Olsen, K.N.; Henriksen, M.; Bisgaard, M.; Nielsen, O.L.; Christensen, H. Investigation of chicken intestinal bacterial communities by 16S rRNA targeted florescence in situ hybridization. Antonie Leeuwenhoek 2008, 94, 423–437. [Google Scholar] [CrossRef] [PubMed]
- Guerre, P. Toxins mycotoxin and gut microbiota interactions. Toxins 2020, 12, 769. [Google Scholar] [CrossRef]
- Fuchs, S.; Sontag, G.; Stidl, R.; Ehrlich, V.; Kundi, M.; Knasmüller, S. Detoxification of patulin and ochratoxin A, two abundant mycotoxins, by lactic acid bacteria. Food Chem. Toxicol. 2008, 46, 1398–1407. [Google Scholar] [CrossRef]
- Farzaneh, M.; Shi, Z.-Q.; Ghassempour, A.; Sedaghat, N.; Ahmadzadeh, M.; Mirabolfathy, M.; Javan-Nikkhah, M. Aflatoxin B1 degradation by Bacillus subtilis UTBSP1 isolated from pistachio nuts of Iran. Food Control 2012, 23, 100–106. [Google Scholar] [CrossRef]
- Guo, Y.; Zhou, J.; Tang, Y.; Ma, Q.; Zhang, J.; Ji, C.; Zhao, L. Characterization and Genome Analysis of a Zearalenone—Degrading Bacillus velezensis Strain ANSB01E. Curr. Microbiol. 2019, 77, 273–278. [Google Scholar] [CrossRef]
- Sadiq, F.A.; Yan, B.; Tian, F.; Zhao, J. Lactic acid bacteria as antifungal and anti-mycotoxigenic agents: A comprehensive review. Compr. Rev. Food Sci. Food Saf. 2019, 18, 1403–1436. [Google Scholar] [CrossRef]
- Sun, F.; Chen, J.; Liu, K.; Tang, M.; Yang, Y. The avian gut microbiota: Diversity, influencing factors, and future directions. Front. Microbiol. 2022, 13, 934272. [Google Scholar] [CrossRef]
- Argôlo-Filho, R.C.; Loguercio, L.L. Bacillus thuringiensis is an environmental pathogen and host-specificity has developed as an adaptation to human-generated ecological niches. Insects 2013, 5, 62–91. [Google Scholar] [CrossRef]
- Mohammadi, B.; Gorkina, N.; Smith, S.A. Pathogenicity, Toxin Production, Control and Detection of Bacillus cereus. In Foodborne Pathogens-Recent Advances in Control and Detection; IntechOpen: London, UK, 2022. [Google Scholar]
- Ehling-Schulz, M.; Lereclus, D.; Koehler, T.M. The Bacillus cereus croup: Bacillus species with pathogenic potential. Microbiol. Spectr. 2019, 7, 10.1128. [Google Scholar] [CrossRef] [PubMed]
- Calvigioni, M.; Cara, A.; Celandroni, F.; Mazzantini, D.; Panattoni, A.; Tirloni, E.; Bernardi, C.; Pinotti, L.; Stella, S.; Ghelardi, E. Characterization of a Bacillus cereus strain associated with a large feed-related outbreak of severe infection in pigs. J. Appl. Microbiol. 2022, 133, 1078–1088. [Google Scholar] [CrossRef] [PubMed]
- Nicholson, W.L. Roles of Bacillus endospores in the environment. Cell. Mol. Life Sci. CMLS 2002, 59, 410–416. [Google Scholar] [CrossRef]
- Smith, D.P.; Berrang, M.E.; Feldner, P.W.; Phillips, R.W.; Meinersmann, R.T.J. Detection of Bacillus cereus on selected retail chicken products. J. Food Prot. 2004, 67, 1770–1773. [Google Scholar] [CrossRef]
- Barbosa, T.M.; Serra, E.R.; La Ragione, R.M.; Woodward, M.J.; Henriques, A.O. Screening for Bacillus isolates in the broiler gastrointestinal tract. Appl. Environ. Microbiol. 2005, 71, 968–978. [Google Scholar] [CrossRef]
- Hong, H.A.; Duc, L.H.; Cutting, S.M. The use of bacterial spore formers as probiotics. FEMS Microbiol. Rev. 2005, 4, 813–835. [Google Scholar] [CrossRef]
- Prince, C.; Kovac, J. Regulation of enterotoxins associated with Bacillus cereus Sensu Lato Toxicoinfection. Appl. Environ. Microbiol. 2022, 88, e00405-22. [Google Scholar] [CrossRef]
- Lee, N.K.; Kim, W.S.; Paik, H.D. Bacillus strains as human probiotics: Characterization, safety, microbiome, and probiotic carrier. Food Sci. Biotechnol. 2019, 28, 1297–1305. [Google Scholar] [CrossRef]
- Han, A.; Yoon, J.-H.; Choi, Y.-S.; Bong, Y.; Jung, G.; Moon, S.-K.; Lee, S.-Y. Toxigenic diversity of Bacillus cereus isolated from fresh produce and effects of various factors on the growth and the cytotoxicity of B. cereus. Food Sci. Biotechnol. 2024, 33, 219–229. [Google Scholar] [CrossRef]
- Díaz-Gómez, J.; Marín, S.; Capell, T.; Sanchis, V.; Ramos, A.J. The impact of Bacillus thuringiensis technology on the occurrence of fumonisins and other mycotoxins in maize. World Mycotoxin J. 2016, 9, 475–486. [Google Scholar] [CrossRef]
- Hassan, Z.U.; Al Thani, R.; Alsafran, M.; Migheli, Q.; Jaoua, S. Selection of Bacillus spp. with decontamination potential on multiple Fusarium mycotoxins. Food Control 2021, 127, 108119. [Google Scholar] [CrossRef]
- Xue, G.; Qu, Y.; Wu, D.; Huang, S.; Che, Y.; Yu, J.; Song, P. Biodegradation of aflatoxin B1 in the Baijiu brewing process by Bacillus cereus. Toxins 2023, 15, 65. [Google Scholar] [CrossRef] [PubMed]
- Harčárová, M.; Čonková, E.; Naď, P.; Proškovcová, M. Zearalenone biodegradation by the Lactobacillus spp. and Bacillus spp. in vitro. Folia Vet. 2022, 66, 70–74. [Google Scholar] [CrossRef]
- Liu, F.; Malaphan, W.; Xing, F.; Yu, B. Biodetoxification of fungal mycotoxins zearalenone by engineered probiotic bacterium Lactobacillus reuteri with surface-displayed lactonohydrolase. Appl. Microbiol. Biotechnol. 2019, 103, 8813–8824. [Google Scholar] [CrossRef]
- Solis-Cruz, B.; Hernandez-Patlan, D.; Hargis, B.; Tellez, G. Control of aflatoxicosis in poultry using probiotics and polymers. In Mycotoxins—Impact and Management Strategies; Njobeh, P.B., Stepman, F., Eds.; IntechOpen: London, UK, 2019. [Google Scholar]
- Walter, P.P.; Tunde, P.; Istvan, P. Mycotoxins-prevention and decontamination by yeast. J. Basic Microbiol. 2015, 55, 805–818. [Google Scholar]
- Luo, Y.; Liu, X.; Yuan, L.; Li, J. Complicated interactions between bio-adsorbents and mycotoxins during mycotoxin adsorption: Current research and future prospects. Trends Food Sci. Technol. 2020, 96, 127–134. [Google Scholar] [CrossRef]
- Umesha, S.; Manukumar, H.M.G.; Chandrasekhar, B.; Shivakumara, P.; Kumar, J.S.; Raghava, S.; Avinash, P.; Shirin, M.; Bharathi, T.R.; Rajini, S.B.; et al. Aflatoxins and food pathogens: Impact of biologically active aflatoxins and their control strategies. J. Sci. Food Agric. 2017, 97, 1698–1707. [Google Scholar] [CrossRef]
- Muhialdin, B.J.; Saari, N.; Hussin, A.S.M. Review on the biological detoxidfication of mycotoxins using lactic acid bacteria to enhance the sustainability of foods supply. Molecules 2020, 25, 2655. [Google Scholar] [CrossRef]
- Chapot-Chartier, M.P.; Kulakauskas, S. Cell wall structure and function in lactic acid bacteria. Microb. Cell Fact. 2014, 13 (Suppl. S1), 1–23. [Google Scholar] [CrossRef]
- Severin, A.; Tabei, K.; Tomasz, A. The structure of the cell wall peptidoglycan of Bacillus cereus RSVF1, a strain closely Related to Bacillus antrhacis. Microb. Drug Resist. 2004, 10, 77–82. [Google Scholar] [CrossRef]
- Leoff, C.; Saile, E.; Sue, D.; Wilkins, P.; Quinn, C.P.; Carlson, R.W.; Kannenberg, E.L. Cell wall carbohydrate compositions of strains from the Bacillus cereus of species correlate with phylogenetic relatedness. J. Bacteriol. 2008, 190, 112–121. [Google Scholar] [CrossRef] [PubMed]
- Zhou, L.H.; Wang, Y.L.; Qiu, M.; Shi, Q.; Sun, L.J.; Liao, J.M.; Xu, D.F.; Liu, Y.; Fang, Z.J.; Gooneratne, R. Analysis of T-2 toxin removal factors in a Lactococcus fermentation system. J. Food Prot. 2017, 80, 1471–1477. [Google Scholar] [CrossRef] [PubMed]
- Bartkiene, E.; Zavistanaviciute, P.; Lele, V.; Ruzauskas, M.; Bartkevics, V.; Bernatoniene, J.; Gallo, P.; Tenore, G.C.; Santini, A. Lactobacillus plantarum LUHS135 and paracasei LUHS244 as functional starter cultures for the food fermentation industry: Characterisation, mycotoxin-reducing properties, optimization of biomass growth and sustainable encapsulation by using dairy by-products. LWT-Food Sci. Technol. 2018, 93, 649–658. [Google Scholar]
- Berthiller, F.; Crews, C.; Dall’Asta, C.; Saeger, S.D.; Haesaert, G.; Karlovsky, P.; Oswald, I.P.; Seefelder, W.; Speijers, G.; Stroka, J. Masked mycotoxins: A review. Mol. Nutr. Food Res. 2013, 57, 165–186. [Google Scholar] [CrossRef] [PubMed]
- Ekwomadu, T.I.; Akinola, S.A.; Mwanza, M. Fusarium mycotoxins, their metabolites (free, emerging, and masked), food safety concerns, and health impacts. Int. J. Environ. Res. Public Health 2021, 18, 11741. [Google Scholar] [CrossRef]
- Veprikova, Z.; Vaclavikova, M.; Lacina, O.; Dzuman, Z.; Zachariasova, M.; Hajslova, J. Occurrence of mono- and di-glycosylated conjugates of T-2 and HT-2 toxins in naturally contaminated cereals. World Mycotoxin J. 2012, 5, 231–240. [Google Scholar] [CrossRef]
- Matsui, K.; Takeda, H.; Shinkai, K.; Kakinuma, T.; Koizumi, Y.; Kase, M.; Yoshinari, T.; Minegishi, H.; Nakajima, Y.; Aikawa, S.; et al. 4-O-Glucosylation of Trichothecenes by Fusarium Species: A Phase II Xenobiotic Metabolism for t-Type Trichothecene Producers. Int. J. Mol. Sci. 2021, 22, 13542. [Google Scholar] [CrossRef]
- Busman, M.; Poling, S.M.; Maragos, C.M. Observation of T-2 toxin and HT-2 toxin glucosides from Fusarium sporotrichioides by liquid chromatography coupled to tandem mass spectrometry (LC-MS/MS). Toxins 2011, 3, 1554–1568. [Google Scholar] [CrossRef]
- Ricci, A.; Cirlini, M.; Calani, L.; Bernini, V.; Neviani, E.; Del Rio, D.D.; Galaverna, G.; Lazzi, C. In vitro metabolism of elderberry juice polyphenols by lactic acid bacteria. Food Chem. 2019, 276, 692–699. [Google Scholar] [CrossRef]

| Type A Trichothecenes Concentration | ||||
|---|---|---|---|---|
| Extract | DAS (µg/mL) | T-2 (µg/mL) | HT-2 (µg/mL) | NEO (µg/mL) |
| 1 | 1.35 | 2.39 | 1.87 | 67.62 |
| 2 | 0 | 257.59 | 1134.63 | 79.17 |
| 3 | 36.84 | 1351.49 | 16.35 | 65.32 |
| I | Nearest Matched Species from GenBank | E-Value | Query-Cover (%) | Identity (%) | GenBank Accession Number |
|---|---|---|---|---|---|
| 1 | Lactiplantibacillus plantarum PP16 | 0 | 99 | 99.61 | MF541084.1 |
| 2 | Bacillus sp. | 0 | 100 | 99.58 | MT810014.1 |
| 3 | Lactiplantibacillus plantarum IMAU98304 | 0 | 95 | 95.29 | MT473659.1 |
| 4 | Limosilactobacillus reuteri V3266 | 0 | 99 | 99.52 | PQ013831 |
| 5 | Bacillus cereus DJ29 | 0 | 100 | 100 | CP162505 |
| Test | Result |
|---|---|
| Trehalose | − |
| Sucrose | − |
| Arabinose | + |
| p-nitrophenyl-β-d-glucoside | + |
| p-nitrophenyl-phosphate | − |
| Urea | − |
| Lactose | − |
| Mannitol | − |
| Glycerol | − |
| p-nitrophenyl-β-d-cellobioside | − |
| p-nitrophenyl-α-d-maltoside | − |
| Escualine | + |
| Methyl-α and -β glucoside | − |
| Maltotriose | − |
| Fructose | + |
| Proline and Leucine-p-nitroanilide | − |
| o-nitrophenyl-β-d-galactoside and p-nitrophenyl-α-d-galactoside | − |
| Arginine | − |
Disclaimer/Publisher’s Note: The statements, opinions and data contained in all publications are solely those of the individual author(s) and contributor(s) and not of MDPI and/or the editor(s). MDPI and/or the editor(s) disclaim responsibility for any injury to people or property resulting from any ideas, methods, instructions or products referred to in the content. |
© 2024 by the authors. Licensee MDPI, Basel, Switzerland. This article is an open access article distributed under the terms and conditions of the Creative Commons Attribution (CC BY) license (https://creativecommons.org/licenses/by/4.0/).
Share and Cite
García-García, F.A.; Cristiani-Urbina, E.; Morales-Barrera, L.; Rodríguez-Peña, O.N.; Hernández-Portilla, L.B.; Campos, J.E.; Flores-Ortíz, C.M. Study of Bacillus cereus as an Effective Multi-Type A Trichothecene Inactivator. Microorganisms 2024, 12, 2236. https://doi.org/10.3390/microorganisms12112236
García-García FA, Cristiani-Urbina E, Morales-Barrera L, Rodríguez-Peña ON, Hernández-Portilla LB, Campos JE, Flores-Ortíz CM. Study of Bacillus cereus as an Effective Multi-Type A Trichothecene Inactivator. Microorganisms. 2024; 12(11):2236. https://doi.org/10.3390/microorganisms12112236
Chicago/Turabian StyleGarcía-García, Fernando Abiram, Eliseo Cristiani-Urbina, Liliana Morales-Barrera, Olga Nelly Rodríguez-Peña, Luis Barbo Hernández-Portilla, Jorge E. Campos, and Cesar Mateo Flores-Ortíz. 2024. "Study of Bacillus cereus as an Effective Multi-Type A Trichothecene Inactivator" Microorganisms 12, no. 11: 2236. https://doi.org/10.3390/microorganisms12112236
APA StyleGarcía-García, F. A., Cristiani-Urbina, E., Morales-Barrera, L., Rodríguez-Peña, O. N., Hernández-Portilla, L. B., Campos, J. E., & Flores-Ortíz, C. M. (2024). Study of Bacillus cereus as an Effective Multi-Type A Trichothecene Inactivator. Microorganisms, 12(11), 2236. https://doi.org/10.3390/microorganisms12112236

